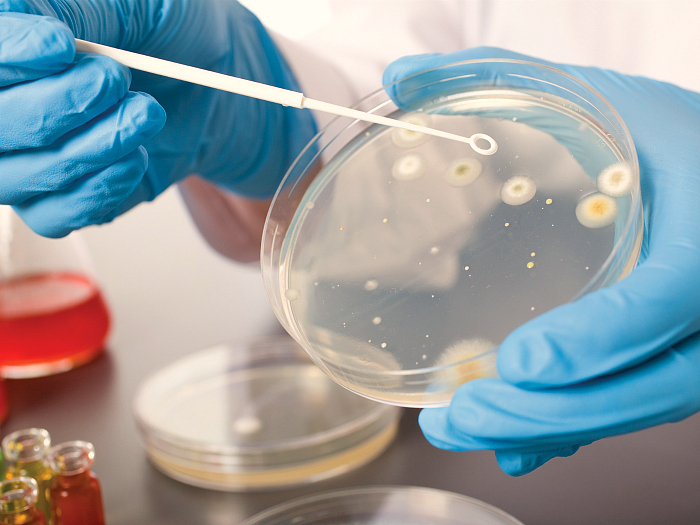
Что такое уреаплазма уреалитикум, как лечить разные виды заражения у женщин и мужчин

Причины и лечение сухости во влагалище после родов, при климаксе и половом акте
Сухость во влагалище возникает из-за низкой выработки эстрогена. Причин нарушенного баланса гормонов может быть несколько - климакс, послеродовое состояние влагалища, нарушения правил личной гигиены или половой акт.
В обязательном порядке необходимо провериться у гинеколога и получить специализированное лечение. Врач должен исключить вероятность онкологических и других серьезных заболеваний, установить правильное гормональное лечение.
Расшифровка спермограммы: норма и нарушения
Спермограмма - исследование эякулята (спермы) в лабораторных условиях. С помощью этого анализа определяются основные параметры фертильности мужчины и возможные воспалительные заболевания в мочеполовой системе. Расшифровкой полученных результатов занимается уролог или андролог. На конечные данные анализов влияет правильность подготовки мужчины к этому исследованию. Спермограмма включает в себя изучение физических и микроскопических свойств эякулята.
Что такое уреаплазма уреалитикум, как лечить разные виды заражения у женщин и мужчин
Уреаплазма уреалитикум - микроорганизм, относящийся к группе микоплазм. Он занимает промежуточное положение между вирусами и бактериями, может проникать внутрь клеток и размножаться там. В организме здорового человека не обнаруживается, но часто сопровождает другие половые инфекции.
Вызывает заболевания у мужчин и женщин, осложняет течение других патологий мочеполовой системы. Поражает не только половые органы, но и другие слизистые оболочки - полости рта, прямой кишки.
Симптомы, пути передачи и лечение трихомониаза у мужчин и женщин
Трихомониаз относится к инфекциям, передающимся половым путем. Болезнь развивается вследствие инфицирования вагинальными трихомонадами и воспаления, вызванного микроорганизмом. Вероятность заразиться бытовым способом крайне мала. Главный путь инфицирования — половой, но некоторые специалисты считают, что заражение может произойти после использования банных принадлежностей, на которых сохранились выделения зараженного.
Trichomonas vaginalis часто несут в себе возбудителей гонореи или хламидиоза, поэтому многие врачи считают, что основную опасность представляют не сами трихомонады, а микроорганизмы, которых они в себе несут.
Что такое вульвит у девочек и как его лечить?
Вульвит – воспалительный процесс, протекающий на наружных половых органах. К ним относятся малые и большие половые губы, отверстие мочеиспускательного канала, клитор и вход во влагалище. Заболевание часто проявляется именно в раннем возрасте. Это связано с анатомическими и физиологическими особенностями девочек. Вульвит требует незамедлительного лечения, поскольку способен вызвать серьезные осложнения.
Это Вам пригодится
Противопоказания лазерной эпиляции: все ли так страшно?
Можно ли забеременеть при приеме противозачаточных таблеток?
Оральные контрацептивы считаются наиболее действенным методом профилактики нежелательной беременности. Но их эффективность зависит от соблюдения правил применения, которые часто нарушаются. Противозачаточные таблетки несовместимы с антибиотиками, их всасывание нарушают и другие средства. Привести к беременности могут и пропуски в применении препаратов, даже однократные. Поэтому зачать при приеме оральных контрацептивов вполне реально. Беременность в этом случае будет обычной, и, как показывает статистика, дети рождаются абсолютно нормальными.
Противозачаточные таблетки для женщин от 40 лет
Для женщин в возрасте 40 лет проблема контрацепции так же актуальна, как и для молодых девушек. В этот период существует вероятность нежелательной беременности, несмотря на то, что функции репродуктивной системы постепенно угасают. В настоящее время самым эффективным методом контрацепции является прием противозачаточных таблеток. Защита от беременности при применении оральных контрацептивов составляет 97–99,9%. Но это не единственное их достоинство.